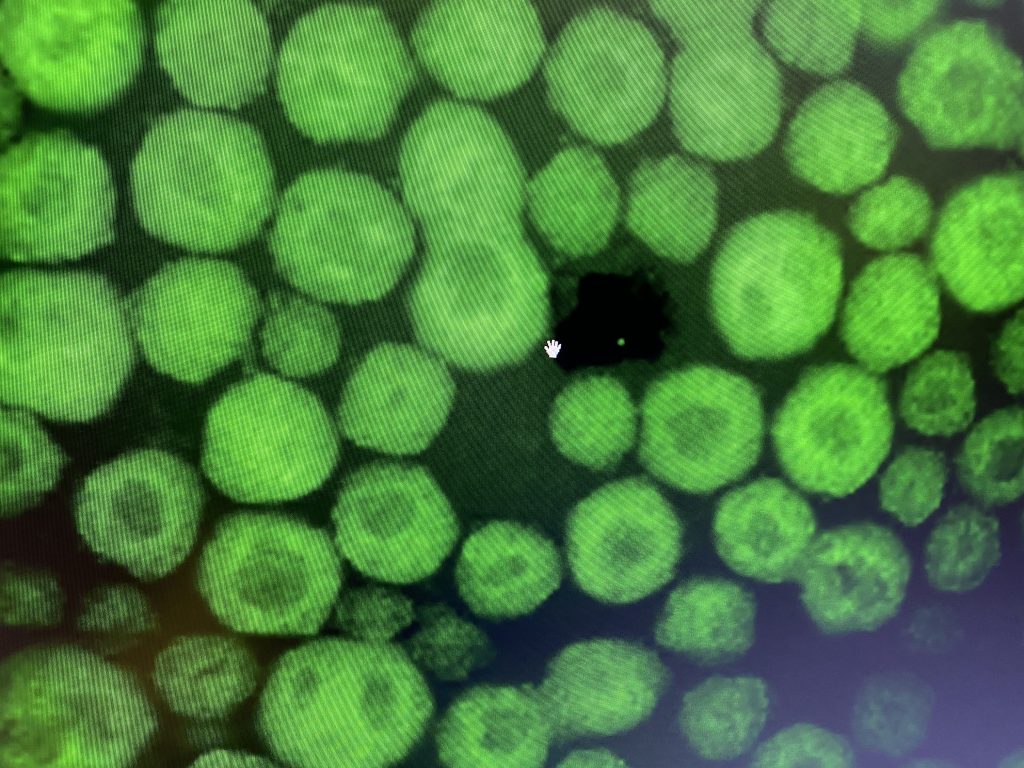

Why does a given neuropathology not impact all neurons of the same type to a similar extent?
This is a fascinating question in neurodegeneration research that remains unanswered and represents the main focus of the Rodríguez-Muela lab.
In most neurodegenerative diseases, certain neuronal subgroups degenerate rapidly while others, carrying the same mutations (if any), subjected to theoretically analogous stress, and displaying comparable functional properties, remain unaffected even at the latest stages of the disease. Motor neuron diseases are a group of disorders in which motor neurons (MNs) of the spinal cord and/or the motor cortex are the primary cell type affected. This perplexing feature can also be observed in these diseases.
Using a variety of approaches, ranging from cellular biology techniques and live imaging to genome editing and single-cell genomics, and utilizing human induced pluripotent stem cells and organoids together with transgenic animal models, we investigate the molecular mechanisms underlying such selective MN death. We devote special focus to exploring the molecular basis of proteostasis failure—a major causative event in neurodegeneration—and to examining the contribution of cell-autonomous and non-cell-autonomous factors to selective MN loss. Our ultimate goal is to understand the molecular origin of this distinctive, selective neuronal vulnerability to design effective therapeutics targeting specific neuronal subtypes or phases of the disease.